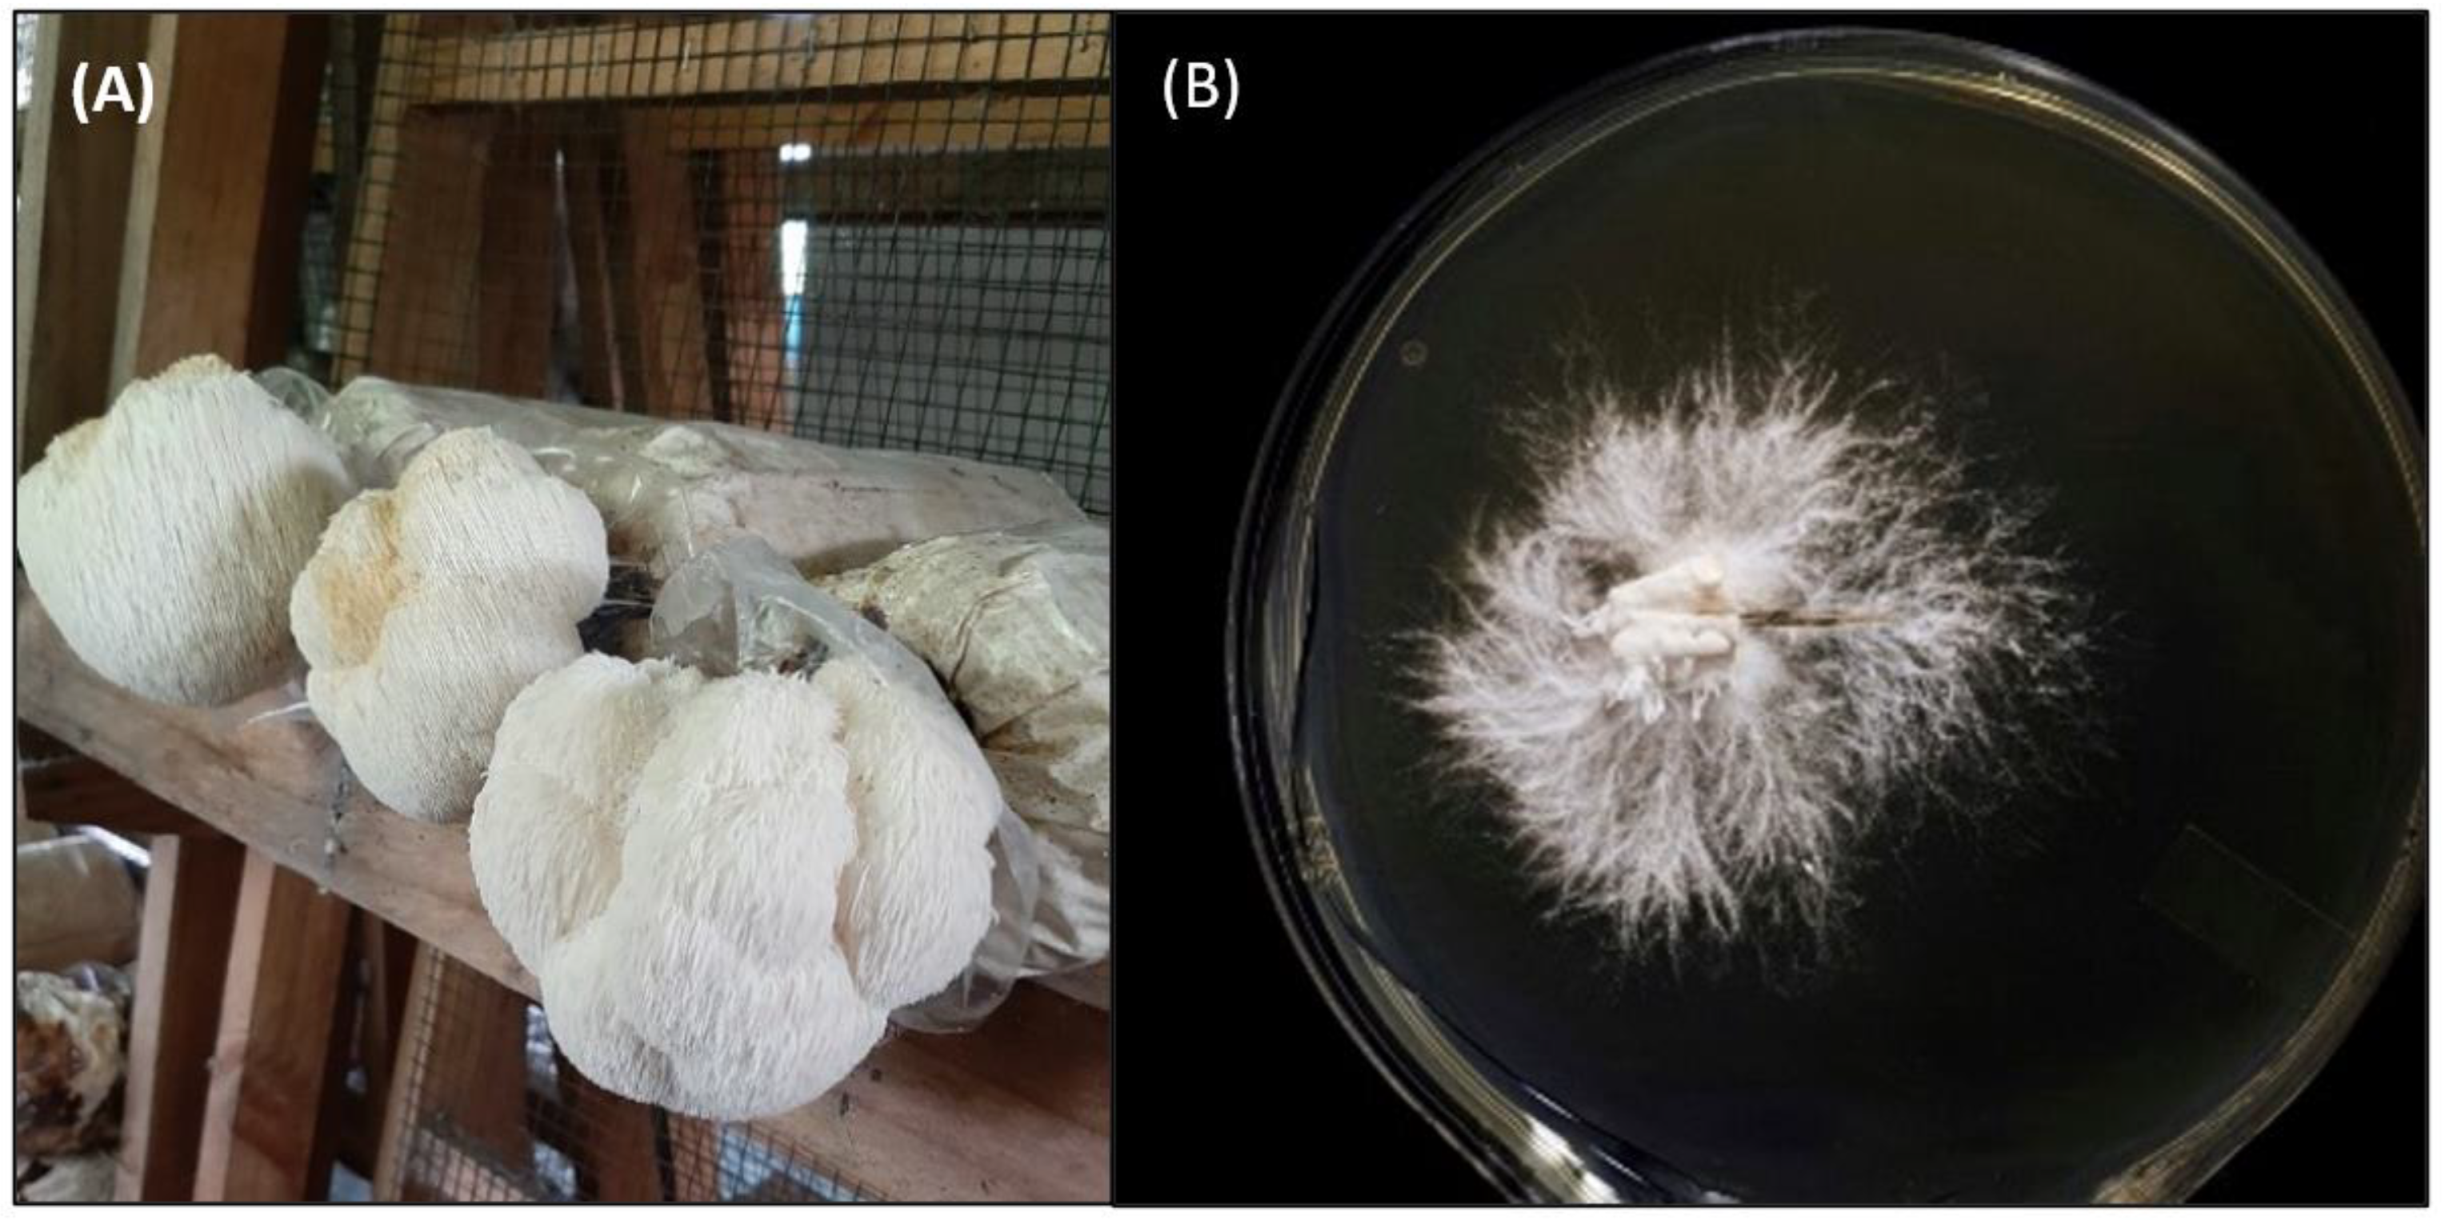

The Monkey Head Mushroom and Memory Enhancement in Alzheimer’s Disease
Abstract
:1. Introduction
2. Etiology of Alzheimer’s Disease
3. Preclinical Studies of Hericium erinaceus in AD
| Authors | Animal Models | Treatment Method | Behavioral Test | Behavioral Outcome | Mechanism and Physiological Effect |
|---|---|---|---|---|---|
| Mori et al., 2011 [48] | 5-week-old male ICR mice with Aβ (25–35) and Aβ (35–25) | 10 μg of amyloid β (25–35) peptide administered intracerebroventricularly on days 7 and 14 and fed with HE diet (powdered mixture of normal diet and HE), containing 5.5% of (w/w) for 23 days | Y-Maze test NOR | No significant difference observed in alternation behavior between Aβ (25–35) and Aβ (35–25) group HE increased exploration time for novel object than for familiar object in Aβ (25–35) mice, but not Aβ (35–25) mice | Increased hippocampal NGF mRNA expression |
| Tsai-Teng et al., 2016 [49] | 5-month-old female APPswe/PS1dE9 double transgenic mice | Short-term: Oral administration of HE-A and HE-Et (300 mg/kg/day) for 30 days Long-term: Oral administration of HE-My (300 mg/kg/day) for 70–90 days | Nesting | HE-My for 81 days improved nesting behaviors | HE-A or HE-Et for 30 days: Eliminated Aβ plaque burden Prevented recruitment and activation of plaque-associated microglia and astrocytes Promoted proliferation of neuron progenitors Increased neuronal proliferation in the dentate gyrus |
| Tzeng et al., 2018 [50] | 5-month-old female APPswe/PS1dE9 double transgenic mice | Short-term: HE-A or HE-S (30 mg/kg/day) administered through gavage with vehicle for 30 days Long-term: Oral administration of HE-A (10 and 30 mg/kg/day) for 100 days | Burrowing Nesting MWM | HE-A ameliorated learning and spatial memory during the probe trial Deficits in spontaneous burrowing behavior significantly recovered at both 10 and 30 mg/kg of HE-A Impaired nesting behavior significantly recovered at 30 mg/kg of HE-A | HE-A and HE-S decreased Aβ plaque burden and increased cerebral Aβ degradation HE-A decreased Aβ accumulation by inhibiting Aβ production in the cerebrum HE-A and HE-S reduced activation of glial cells in the cerebrum HE-A and HE-S promoted neurogenesis and dendritic complexity in the hippocampus |
| Zhang et al., 2016 [47] | 10-week-old Balb/c female mice with 120 mg/kg of D-gal 20 mg/kg of kg of AlCl3 | Subcutaneous injection of 120 mg/kg of D-gal and intragastric administration of 20 mg/kg of AlCl3 once per day for 10 weeks Intragastric administration of polysaccharide-enriched aqueous extract of HE mycelia at dose of 0.3, 1.0, and 3.0 g/kg for 4 weeks | Autonomic activities test MWM Fatigue rotarod test | HE enhanced vertical and horizontal movements in the autonomic activity test HE ameliorated rotarod test endurance time HE reduced MWM escape latency time | Increasing the dose of HE-enhanced AChE and ChAT concentrations in the serum and hypothalamus |
| Cordaro et al., 2021 [58] | 6–8-week-old male Wistar rats with AlCl3 | Intraperitoneally administered 70 mg/kg of AlCl3 daily for 6 weeks Control + HE: Oral administration of HE (200 mg/kg) daily by gavage AD + HE: Oral administration of HE (200 mg/kg) daily by gavage | MWM EPM NOR | HE increased animal permanence in target quadrant HE increased time of novel object recognition with high discrimination ratio | HE reduced AlCl3-induced CA1 neuronal degeneration HE increased Nrf2 expression in the hippocampus HE increased antioxidant defense including SOD, CAT, and GSH levels HE reduced NLRP3 inflammasome activation HE decreased phosphorylated Tau, APP overexpression, and Aβ aggregation |
| Lee et al., 2021 [59] | 3-month-old male and female (SAMP8) mice | Low-dose group (108 mg/kg/bw/day), intermediate-dose group (215 mg/kg/bw/day), and high-dose group (431 mg/kg/bw/day) of oral HE-A administration for 13 weeks | Passive Avoidance Task Active Shuttle Avoidance Task | HE-A significantly increased number of avoidance responses Latency time after training increased for passive avoidance test in HE-A groups | HE-A lowered iNOS expression, lowering oxidative stress/inflammation HE-A decreased TBARS levels, decreasing lipid peroxidation HE-A resulted in a downward trend in Aβ plaque (%) |
4. Clinical Studies of Hericium erinaceus in AD
5. Mechanisms of Hericium erinaceus in AD
5.1. Anti-Amyloidogenic Functions
5.2. Anti-Oxidative Function
5.3. Anti-Neuroinflammation
5.4. Neurotrophic Mechanisms
5.5. Neurotransmission
6. Limitations and Future Perspective
7. Conclusions
Author Contributions
Funding
Institutional Review Board Statement
Informed Consent Statement
Data Availability Statement
Acknowledgments
Conflicts of Interest
References
- Kumar, A.; Sidhu, J.; Goyal, A.; Tsao, J.W. Alzheimer Disease. In StatPearls; StatPearls Publishing LLC.: Treasure Island, FL, USA, 2021. [Google Scholar]
- Yuan, J.; Zhang, Z.; Wen, H.; Hong, X.; Hong, Z.; Qu, Q.; Tang, M.; Wu, J.; Xu, Q.; Li, H.; et al. Incidence of dementia and subtypes: A cohort study in four regions in China. Alzheimer’s Dement. 2016, 12, 262–271. [Google Scholar] [CrossRef] [PubMed]
- Poon, C.H.; Wang, Y.; Fung, M.L.; Zhang, C.; Lim, L.W. Rodent Models of Amyloid-Beta Feature of Alzheimer’s Disease: Development and Potential Treatment Implications. Aging Dis. 2020, 11, 1235–1259. [Google Scholar] [CrossRef]
- Uddin, M.S.; Lim, L.W. Glial cells in Alzheimer’s disease: From neuropathological changes to therapeutic implications. Ageing Res. Rev. 2022, 78, 101622. [Google Scholar] [CrossRef]
- Wong, K.Y.; Roy, J.; Fung, M.L.; Heng, B.C.; Zhang, C.; Lim, L.W. Relationships between Mitochondrial Dysfunction and Neurotransmission Failure in Alzheimer’s Disease. Aging Dis. 2020, 11, 1291–1316. [Google Scholar] [CrossRef]
- Lanctôt, K.L.; Rajaram, R.D.; Herrmann, N. Therapy for Alzheimer’s Disease: How Effective are Current Treatments? Adv. Neurol. Disord. 2009, 2, 163–180. [Google Scholar] [CrossRef] [PubMed] [Green Version]
- Tanaka, M.; Török, N.; Vécsei, L. Novel Pharmaceutical Approaches in Dementia. NeuroPsychopharmacotherapy 2020, 1–18. [Google Scholar] [CrossRef]
- Breijyeh, Z.; Karaman, R. Comprehensive Review on Alzheimer’s Disease: Causes and Treatment. Molecules 2020, 25, 5789. [Google Scholar] [CrossRef]
- Shega, J.W.; Ellner, L.; Lau, D.T.; Maxwell, T.L. Cholinesterase inhibitor and N-methyl-D-aspartic acid receptor antagonist use in older adults with end-stage dementia: A survey of hospice medical directors. J. Palliat. Med. 2009, 12, 779–783. [Google Scholar] [CrossRef]
- Chan, H.J.; Yanshree; Roy, J.; Tipoe, G.L.; Fung, M.-L.; Lim, L.W. Therapeutic Potential of Human Stem Cell Implantation in Alzheimer’s Disease. Int. J. Mol. Sci. 2021, 22, 10151. [Google Scholar] [CrossRef]
- Liu, J.; Chang, L.; Song, Y.; Li, H.; Wu, Y. The Role of NMDA Receptors in Alzheimer’s Disease. Front. Neurosci. 2019, 13, 43. [Google Scholar] [CrossRef] [Green Version]
- Uddin, M.S.; Kabir, M.T.; Rahman, M.S.; Behl, T.; Jeandet, P.; Ashraf, G.M.; Najda, A.; Bin-Jumah, M.N.; El-Seedi, H.R.; Abdel-Daim, M.M. Revisiting the Amyloid Cascade Hypothesis: From Anti-Aβ Therapeutics to Auspicious New Ways for Alzheimer’s Disease. Int. J. Mol. Sci. 2020, 21, 5858. [Google Scholar] [CrossRef]
- Congdon, E.E.; Sigurdsson, E.M. Tau-targeting therapies for Alzheimer disease. Nat. Rev. Neurol. 2018, 14, 399–415. [Google Scholar] [CrossRef] [PubMed]
- Tan, S.Z.K.; Lim, L.W. A practical approach to the ethical use of memory modulating technologies. BMC Med. Ethics 2020, 21, 89. [Google Scholar] [CrossRef] [PubMed]
- Tan, S.Z.K.; Zhao, R.C.; Chakrabarti, S.; Stambler, I.; Jin, K.; Lim, L.W. Interdisciplinary Research in Alzheimer’s Disease and the Roles International Societies Can Play. Aging Dis. 2021, 12, 36–41. [Google Scholar] [CrossRef] [PubMed]
- Chong, P.S.; Fung, M.-L.; Wong, K.H.; Lim, L.W. Therapeutic Potential of Hericium erinaceus for Depressive Disorder. Int. J. Mol. Sci. 2020, 21, 163. [Google Scholar] [CrossRef] [Green Version]
- Chong, P.S.; Khairuddin, S.; Tse, A.C.K.; Hiew, L.F.; Lau, C.L.; Tipoe, G.L.; Fung, M.-L.; Wong, K.H.; Lim, L.W. Hericium erinaceus potentially rescues behavioural motor deficits through ERK-CREB-PSD95 neuroprotective mechanisms in rat model of 3-acetylpyridine-induced cerebellar ataxia. Sci. Rep. 2020, 10, 14945. [Google Scholar] [CrossRef]
- Thongbai, B.; Rapior, S.; Hyde, K.D.; Wittstein, K.; Stadler, M. Hericium erinaceus, an amazing medicinal mushroom. Mycol. Prog. 2015, 14, 91. [Google Scholar] [CrossRef]
- Lew, S.Y.; Lim, S.H.; Lim, L.W.; Wong, K.H. Neuroprotective effects of Hericium erinaceus (Bull.: Fr.) Pers. against high-dose corticosterone-induced oxidative stress in PC-12 cells. BMC Complement. Med. Ther. 2020, 20, 340. [Google Scholar] [CrossRef]
- Lew, S.-Y.; Yow, Y.-Y.; Lim, L.-W.; Wong, K.-H. Antioxidant-mediated protective role of Hericium erinaceus (Bull.: Fr.) Pers. against oxidative damage in fibroblasts from Friedreich’s ataxia patient. Food Sci. Technol. 2020, 40, 264–272. [Google Scholar] [CrossRef] [Green Version]
- Wong, K.H.; Naidu, M.; David, P.; Abdulla, M.A.; Abdullah, N.; Kuppusamy, U.R.; Sabaratnam, V. Peripheral Nerve Regeneration Following Crush Injury to Rat Peroneal Nerve by Aqueous Extract of Medicinal Mushroom Hericium erinaceus (Bull.: Fr) Pers. (Aphyllophoromycetideae). Evid.-Based Complement. Altern. Med. 2011, 2011, 580752. [Google Scholar] [CrossRef] [Green Version]
- Samberkar, S.; Gandhi, S.; Naidu, M.; Wong, K.H.; Raman, J.; Sabaratnam, V. Lion’s Mane, Hericium erinaceus and Tiger Milk, Lignosus rhinocerotis (Higher Basidiomycetes) Medicinal Mushrooms Stimulate Neurite Outgrowth in Dissociated Cells of Brain, Spinal Cord, and Retina: An In Vitro Study. Int. J. Med. Mushrooms 2015, 17, 1047–1054. [Google Scholar] [CrossRef] [PubMed] [Green Version]
- Chong, P.S.; Poon, C.H.; Roy, J.; Tsui, K.C.; Lew, S.Y.; Phang, M.W.L.; Tan, R.J.Y.; Cheng, P.G.; Fung, M.L.; Wong, K.H.; et al. Neurogenesis-dependent antidepressant-like activity of Hericium erinaceus in an animal model of depression. Chin. Med. 2021, 16, 132. [Google Scholar] [CrossRef] [PubMed]
- Yow, Y.Y.; Goh, T.K.; Nyiew, K.Y.; Lim, L.W.; Phang, S.M.; Lim, S.H.; Ratnayeke, S.; Wong, K.H. Therapeutic Potential of Complementary and Alternative Medicines in Peripheral Nerve Regeneration: A Systematic Review. Cells 2021, 10, 2194. [Google Scholar] [CrossRef]
- Kah Hui, W.; Sabaratnam, V.; Abdullah, N.; Kuppusamy, U.R.; Naidu, M. Effects of Cultivation Techniques and Processing on Antimicrobial and Antioxidant Activities of Hericium erinaceus (Bull.:Fr.) Pers. Extracts. Food Technol. Biotechnol. 2008, 47, 47–55. [Google Scholar]
- Zhang, C.-C.; Yin, X.; Cao, C.-Y.; Wei, J.; Zhang, Q.; Gao, J.-M. Chemical constituents from Hericium erinaceus and their ability to stimulate NGF-mediated neurite outgrowth on PC12 cells. Bioorg. Med. Chem. Lett. 2015, 25, 5078–5082. [Google Scholar] [CrossRef]
- Kushairi, N.; Tarmizi, N.A.K.A.; Phan, C.W.; Macreadie, I.; Sabaratnam, V.; Naidu, M.; David, P. Modulation of neuroinflammatory pathways by medicinal mushrooms, with particular relevance to Alzheimer’s disease. Trends Food Sci. Technol. 2020, 104, 153–162. [Google Scholar] [CrossRef]
- Sadigh-Eteghad, S.; Sabermarouf, B.; Majdi, A.; Talebi, M.; Farhoudi, M.; Mahmoudi, J. Amyloid-Beta: A Crucial Factor in Alzheimer’s Disease. Med. Princ. Pract. 2015, 24, 1–10. [Google Scholar] [CrossRef]
- He, P.; Shen, Y. Interruption of β-Catenin Signaling Reduces Neurogenesis in Alzheimer’s Disease. J. Neurosci. 2009, 29, 6545. [Google Scholar] [CrossRef] [Green Version]
- Phiel, C.J.; Wilson, C.A.; Lee, V.M.; Klein, P.S. GSK-3alpha regulates production of Alzheimer’s disease amyloid-beta peptides. Nature 2003, 423, 435–439. [Google Scholar] [CrossRef]
- Serrano-Pozo, A.; Frosch, M.P.; Masliah, E.; Hyman, B.T. Neuropathological alterations in Alzheimer disease. Cold Spring Harb. Perspect. Med. 2011, 1, a006189. [Google Scholar] [CrossRef]
- Komuro, Y.; Xu, G.; Bhaskar, K.; Lamb, B.T. Human tau expression reduces adult neurogenesis in a mouse model of tauopathy. Neurobiol. Aging 2015, 36, 2034–2042. [Google Scholar] [CrossRef] [PubMed] [Green Version]
- Rajmohan, R.; Reddy, P.H. Amyloid-Beta and Phosphorylated Tau Accumulations Cause Abnormalities at Synapses of Alzheimer’s disease Neurons. J. Alzheimer’s Dis. 2017, 57, 975–999. [Google Scholar] [CrossRef] [PubMed] [Green Version]
- Poddar, M.K.; Apala, C.; Soumyabrata, B. Neurodegeneration: Diagnosis, Prevention, and Therapy In Oxidoreductase; Mahmoud Ahmed Mansour, M.A., Blumenberg, M., Eds.; IntechOpen: London, UK, 2021; pp. 131–167. [Google Scholar]
- Singh, A.; Kukreti, R.; Saso, L.; Kukreti, S. Oxidative Stress: A Key Modulator in Neurodegenerative Diseases. Molecules 2019, 24, 1583. [Google Scholar] [CrossRef] [PubMed] [Green Version]
- Kim, G.H.; Kim, J.E.; Rhie, S.J.; Yoon, S. The Role of Oxidative Stress in Neurodegenerative Diseases. Exp. Neurobiol. 2015, 24, 325–340. [Google Scholar] [CrossRef] [PubMed]
- Uttara, B.; Singh, A.V.; Zamboni, P.; Mahajan, R.T. Oxidative stress and neurodegenerative diseases: A review of upstream and downstream antioxidant therapeutic options. Curr. Neuropharmacol. 2009, 7, 65–74. [Google Scholar] [CrossRef] [Green Version]
- Guzman-Martinez, L.; Maccioni, R.B.; Andrade, V.; Navarrete, L.P.; Pastor, M.G.; Ramos-Escobar, N. Neuroinflammation as a Common Feature of Neurodegenerative Disorders. Front. Pharmacol. 2019, 10, 1008. [Google Scholar] [CrossRef] [Green Version]
- Harry, G.J.; Kraft, A.D. Neuroinflammation and microglia: Considerations and approaches for neurotoxicity assessment. Expert Opin. Drug Metab. Toxicol. 2008, 4, 1265–1277. [Google Scholar] [CrossRef]
- Pekny, M.; Pekna, M. Reactive gliosis in the pathogenesis of CNS diseases. Biochim. Biophys. Acta-Mol. Basis Dis. 2016, 1862, 483–491. [Google Scholar] [CrossRef]
- Sun, X.; Chen, W.-D.; Wang, Y.-D. β-Amyloid: The Key Peptide in the Pathogenesis of Alzheimer’s Disease. Front. Pharmacol. 2015, 6, 221. [Google Scholar] [CrossRef] [Green Version]
- Slotkin, T.A.; Seidler, F.J.; Crain, B.J.; Bell, J.M.; Bissette, G.; Nemeroff, C.B. Regulatory changes in presynaptic cholinergic function assessed in rapid autopsy material from patients with Alzheimer disease: Implications for etiology and therapy. Proc. Natl. Acad. Sci. USA 1990, 87, 2452–2455. [Google Scholar] [CrossRef] [Green Version]
- Schliebs, R.; Arendt, T. The significance of the cholinergic system in the brain during aging and in Alzheimer’s disease. J. Neural Transm. 2006, 113, 1625–1644. [Google Scholar] [CrossRef] [PubMed]
- García-Ayllón, M.-S.; Small, D.H.; Avila, J.; Saez-Valero, J. Revisiting the Role of Acetylcholinesterase in Alzheimer’s Disease: Cross-Talk with P-tau and β-Amyloid. Front. Mol. Neurosci. 2011, 4, 22. [Google Scholar] [CrossRef] [Green Version]
- Strac, D.S.; Muck-Seler, D.; Pivac, N. Neurotransmitter measures in the cerebrospinal fluid of patients with Alzheimer’s disease: A review. Psychiatr. Danub. 2015, 27, 14–24. [Google Scholar] [PubMed]
- Kandimalla, R.; Reddy, P.H. Therapeutics of Neurotransmitters in Alzheimer’s Disease. J. Alzheimer’s Dis. 2017, 57, 1049–1069. [Google Scholar] [CrossRef] [PubMed] [Green Version]
- Zhang, J.; An, S.; Hu, W.; Teng, M.; Wang, X.; Qu, Y.; Liu, Y.; Yuan, Y.; Wang, D. The Neuroprotective Properties of Hericium erinaceus in Glutamate-Damaged Differentiated PC12 Cells and an Alzheimer’s Disease Mouse Model. Int. J. Mol. Sci. 2016, 17, 1810. [Google Scholar] [CrossRef] [PubMed]
- Mori, K.; Obara, Y.; Moriya, T.; Inatomi, S.; Nakahata, N. Effects of Hericium erinaceus on amyloid β(25-35) peptide-induced learning and memory deficits in mice. Biomed. Res. 2011, 32, 67–72. [Google Scholar] [CrossRef] [PubMed] [Green Version]
- Tsai-Teng, T.; Chin-Chu, C.; Li-Ya, L.; Wan-Ping, C.; Chung-Kuang, L.; Chien-Chang, S.; Chi-Ying, H.F.; Chien-Chih, C.; Shiao, Y.-J. Erinacine A-enriched Hericium erinaceus mycelium ameliorates Alzheimer’s disease-related pathologies in APPswe/PS1dE9 transgenic mice. J. Biomed. Sci. 2016, 23, 49. [Google Scholar] [CrossRef] [Green Version]
- Tzeng, T.-T.; Chen, C.-C.; Chen, C.-C.; Tsay, H.-J.; Lee, L.-Y.; Chen, W.-P.; Shen, C.-C.; Shiao, Y.-J. The Cyanthin Diterpenoid and Sesterterpene Constituents of Hericium erinaceus Mycelium Ameliorate Alzheimer’s Disease-Related Pathologies in APP/PS1 Transgenic Mice. Int. J. Mol. Sci. 2018, 19, 598. [Google Scholar] [CrossRef] [Green Version]
- Sabaratnam, V.; Kah-Hui, W.; Naidu, M.; Rosie David, P. Neuronal health—Can culinary and medicinal mushrooms help? J. Tradit. Complement. Med. 2013, 3, 62–68. [Google Scholar] [CrossRef] [Green Version]
- Park, Y.S.; Lee, H.S.; Won, M.H.; Lee, J.H.; Lee, S.Y.; Lee, H.Y. Effect of an exo-polysaccharide from the culture broth of Hericium erinaceus on enhancement of growth and differentiation of rat adrenal nerve cells. Cytotechnology 2002, 39, 155–162. [Google Scholar] [CrossRef]
- Kah Hui, W.; Sabaratnam, V.; Abdullah, N.; Naidu, M.; Keynes, R. Activity of Aqueous Extracts of Lion’s Mane Mushroom Hericium erinaceus (Bull.: Fr.) Pers. (Aphyllophoromycetideae) on the Neural Cell Line NG108-15. Int. J. Med. Mushrooms 2007, 9, 57–65. [Google Scholar] [CrossRef]
- Kawagishi, H.; Shimada, A.; Shirai, R.; Okamoto, K.; Ojima, F.; Sakamoto, H.; Ishiguro, Y.; Furukawa, S. Erinacines A, B and C, strong stimulators of nerve growth factor (NGF)-synthesis, from the mycelia of Hericium erinaceum. Tetrahedron Lett. 1994, 35, 1569–1572. [Google Scholar] [CrossRef]
- Nagai, K.; Chiba, A.; Nishino, T.; Kubota, T.; Kawagishi, H. Dilinoleoyl-phosphatidylethanolamine from Hericium erinaceum protects against ER stress-dependent Neuro2a cell death via protein kinase C pathway. J. Nutr. Biochem. 2006, 17, 525–530. [Google Scholar] [CrossRef] [PubMed]
- Uddin, M.S.; Yu, W.S.; Lim, L.W. Exploring ER stress response in cellular aging and neuroinflammation in Alzheimer’s disease. Ageing Res. Rev. 2021, 70, 101417. [Google Scholar] [CrossRef]
- Filali, M.; Lalonde, R. Age-related cognitive decline and nesting behavior in an APPswe/PS1 bigenic model of Alzheimer’s disease. Brain Res. 2009, 1292, 93–99. [Google Scholar] [CrossRef]
- Cordaro, M.; Salinaro, A.T.; Siracusa, R.; D’Amico, R.; Impellizzeri, D.; Scuto, M.; Ontario, M.L.; Cuzzocrea, S.; Di Paola, R.; Fusco, R.; et al. Key Mechanisms and Potential Implications of Hericium erinaceus in NLRP3 Inflammasome Activation by Reactive Oxygen Species during Alzheimer’s Disease. Antioxidants 2021, 10, 1664. [Google Scholar] [CrossRef]
- Lee, L.-Y.; Chou, W.; Chen, W.-P.; Wang, M.-F.; Chen, Y.-J.; Chen, C.-C.; Tung, K.-C. Erinacine A-Enriched Hericium erinaceus Mycelium Delays Progression of Age-Related Cognitive Decline in Senescence Accelerated Mouse Prone 8 (SAMP8) Mice. Nutrients 2021, 13, 3659. [Google Scholar] [CrossRef]
- Li, I.C.; Chang, H.H.; Lin, C.H.; Chen, W.P.; Lu, T.H.; Lee, L.Y.; Chen, Y.W.; Chen, Y.P.; Chen, C.C.; Lin, D.P. Prevention of Early Alzheimer’s Disease by Erinacine A-Enriched Hericium erinaceus Mycelia Pilot Double-Blind Placebo-Controlled Study. Front. Aging Neurosci. 2020, 12, 155. [Google Scholar] [CrossRef]
- Mori, K.; Inatomi, S.; Ouchi, K.; Azumi, Y.; Tuchida, T. Improving effects of the mushroom Yamabushitake (Hericium erinaceus) on mild cognitive impairment: A double-blind placebo-controlled clinical trial. Phytother. Res. 2009, 23, 367–372. [Google Scholar] [CrossRef]
- Saitsu, Y.; Nishide, A.; Kikushima, K.; Shimizu, K.; Ohnuki, K. Improvement of cognitive functions by oral intake of Hericium erinaceus. Biomed. Res. 2019, 40, 125–131. [Google Scholar] [CrossRef] [Green Version]
- Li, I.C.; Lee, L.-Y.; Tzeng, T.-T.; Chen, W.-P.; Chen, Y.-P.; Shiao, Y.-J.; Chen, C.-C. Neurohealth Properties of Hericium erinaceus Mycelia Enriched with Erinacines. Behav. Neurol. 2018, 2018, 5802634. [Google Scholar] [CrossRef] [PubMed] [Green Version]
- Lee, A.Y. Vascular dementia. Chonnam Med. J. 2011, 47, 66–71. [Google Scholar] [CrossRef] [PubMed] [Green Version]
- Qiu, W.Q.; Folstein, M.F. Insulin, insulin-degrading enzyme and amyloid-beta peptide in Alzheimer’s disease: Review and hypothesis. Neurobiol. Aging 2006, 27, 190–198. [Google Scholar] [CrossRef] [PubMed]
- Farris, W.; Mansourian, S.; Leissring, M.A.; Eckman, E.A.; Bertram, L.; Eckman, C.B.; Tanzi, R.E.; Selkoe, D.J. Partial Loss-of-Function Mutations in Insulin-Degrading Enzyme that Induce Diabetes also Impair Degradation of Amyloid β-Protein. Am. J. Pathol. 2004, 164, 1425–1434. [Google Scholar] [CrossRef]
- Cook, D.G.; Leverenz, J.B.; McMillan, P.J.; Kulstad, J.J.; Ericksen, S.; Roth, R.A.; Schellenberg, G.D.; Jin, L.-W.; Kovacina, K.S.; Craft, S. Reduced Hippocampal Insulin-Degrading Enzyme in Late-Onset Alzheimer’s Disease Is Associated with the Apolipoprotein E-ε4 Allele. Am. J. Pathol. 2003, 162, 313–319. [Google Scholar] [CrossRef]
- Liang, B.; Guo, Z.; Xie, F.; Zhao, A. Antihyperglycemic and antihyperlipidemic activities of aqueous extract of Hericium erinaceus in experimental diabetic rats. BMC Complement. Altern. Med. 2013, 13, 253. [Google Scholar] [CrossRef] [Green Version]
- Bellezza, I.; Giambanco, I.; Minelli, A.; Donato, R. Nrf2-Keap1 signaling in oxidative and reductive stress. Biochim. Biophys. Acta (BBA)-Mol. Cell Res. 2018, 1865, 721–733. [Google Scholar] [CrossRef]
- Montine, T.J.; Neely, M.D.; Quinn, J.F.; Beal, M.F.; Markesbery, W.R.; Roberts, L.J.; Morrow, J.D. Lipid peroxidation in aging brain and Alzheimer’s disease. Free Radic. Biol. Med. 2002, 33, 620–626. [Google Scholar] [CrossRef]
- Chang, C.-H.; Chen, Y.; Yew, X.-X.; Chen, H.-X.; Kim, J.-X.; Chang, C.-C.; Peng, C.-C.; Peng, R.Y. Improvement of erinacine A productivity in Hericium erinaceus mycelia and its neuroprotective bioactivity against the glutamate-insulted apoptosis. LWT-Food Sci. Technol. 2016, 65, 1100–1108. [Google Scholar] [CrossRef]
- Kim, Y.K.; Shin, J.S.; Nahm, M.H. NOD-Like Receptors in Infection, Immunity, and Diseases. Yonsei Med. J. 2016, 57, 5–14. [Google Scholar] [CrossRef] [Green Version]
- Davis, B.K.; Wen, H.; Ting, J.P.-Y. The Inflammasome NLRs in Immunity, Inflammation, and Associated Diseases. Annu. Rev. Immunol. 2011, 29, 707–735. [Google Scholar] [CrossRef] [PubMed] [Green Version]
- Malinski, T. Nitric oxide and nitroxidative stress in Alzheimer’s disease. J. Alzheimer’s Dis. 2007, 11, 207–218. [Google Scholar] [CrossRef] [PubMed]
- Mori, K.; Obara, Y.; Hirota, M.; Azumi, Y.; Kinugasa, S.; Inatomi, S.; Nakahata, N. Nerve Growth Factor-Inducing Activity of Hericium erinaceus in 1321N1 Human Astrocytoma Cells. Biol. Pharm. Bull. 2008, 31, 1727–1732. [Google Scholar] [CrossRef] [Green Version]
- Ji, S.; Wu, H.; Ding, X.; Chen, Q.; Jin, X.; Yu, J.; Yang, M. Increased hippocampal TrkA expression ameliorates cranial radiation-induced neurogenesis impairment and cognitive deficit via PI3K/AKT signaling. Oncol. Rep. 2020, 44, 2527–2536. [Google Scholar] [CrossRef] [PubMed]
- Martorana, F.; Gaglio, D.; Bianco, M.R.; Aprea, F.; Virtuoso, A.; Bonanomi, M.; Alberghina, L.; Papa, M.; Colangelo, A.M. Differentiation by nerve growth factor (NGF) involves mechanisms of crosstalk between energy homeostasis and mitochondrial remodeling. Cell Death Dis. 2018, 9, 391. [Google Scholar] [CrossRef] [PubMed]
- Hericium erinaceus Extract Reduces Anxiety and Depressive Behaviors by Promoting Hippocampal Neurogenesis in the Adult Mouse Brain. J. Med. Food 2018, 21, 174–180. [CrossRef]
- Brandalise, F.; Cesaroni, V.; Gregori, A.; Repetti, M.; Romano, C.; Orrù, G.; Botta, L.; Girometta, C.; Guglielminetti, M.L.; Savino, E.; et al. Dietary Supplementation of Hericium erinaceus Increases Mossy Fiber-CA3 Hippocampal Neurotransmission and Recognition Memory in Wild-Type Mice. Evid.-Based Complement. Altern. Med. 2017, 2017, 3864340. [Google Scholar] [CrossRef] [PubMed] [Green Version]
- John, P.A.; Wong, K.H.; Naidu, M.; Sabaratnam, V.; David, P. Combination Effects of Curcumin and Aqueous Extract of Lignosus rhinocerotis Mycelium on Neurite Outgrowth Stimulation Activity in PC-12 Cells. Nat. Prod. Commun. 2013, 8, 1934578X1300800. [Google Scholar] [CrossRef] [Green Version]
- Phang, M.W.L.; Lew, S.Y.; Chung, I.; Lim, W.K.; Lim, L.W.; Wong, K.H. Therapeutic roles of natural remedies in combating hereditary ataxia: A systematic review. Chin. Med. 2021, 16, 15. [Google Scholar] [CrossRef]
- Liu, S.H.; Chuang, W.C.; Lam, W.; Jiang, Z.; Cheng, Y.C. Safety surveillance of traditional Chinese medicine: Current and future. Drug Saf. 2015, 38, 117–128. [Google Scholar] [CrossRef] [Green Version]
- Wang, C.; Su, W.; Su, X.; Ni, G.; Liu, T.; Kong, Y. Synergy Effects of Three Plant Extracts on Protection of Gastric Mucosa. Nat. Prod. Commun. 2015, 10, 1989–1991. [Google Scholar] [CrossRef] [PubMed] [Green Version]
- Vaiserman, A.; Koliada, A.; Zayachkivska, A.; Lushchak, O. Nanodelivery of Natural Antioxidants: An Anti-aging Perspective. Front. Bioeng. Biotechnol. 2019, 7, 447. [Google Scholar] [CrossRef] [Green Version]
- Liu, A.; Jain, N.; Vyas, A.; Lim, L.W. Ventromedial prefrontal cortex stimulation enhances memory and hippocampal neurogenesis in the middle-aged rats. eLife 2015, 4, e04803. [Google Scholar] [CrossRef] [PubMed]
- Tan, S.Z.K.; Neoh, J.; Lawrence, A.J.; Wu, E.X.; Lim, L.W. Prelimbic Cortical Stimulation Improves Spatial Memory Through Distinct Patterns of Hippocampal Gene Expression in Aged Rats. Neurotherapeutics 2020, 17, 2054–2068. [Google Scholar] [CrossRef]
- Tan, S.Z.K.; Poon, C.H.; Chan, Y.S.; Lim, L.W. Prelimbic cortical stimulation disrupts fear memory consolidation through ventral hippocampal dopamine D2 receptors. Br. J. Pharm. 2021, 178, 3587–3601. [Google Scholar] [CrossRef] [PubMed]
- Yu, W.S.; Aquili, L.; Wong, K.H.; Lo, A.C.Y.; Chan, L.L.H.; Chan, Y.S.; Lim, L.W. Transcorneal electrical stimulation enhances cognitive functions in aged and 5XFAD mouse models. Ann. N. Y. Acad. Sci. 2022. [Google Scholar] [CrossRef] [PubMed]
- Yu, W.S.; Tse, A.C.; Guan, L.; Chiu, J.L.Y.; Tan, S.Z.K.; Khairuddin, S.; Agadagba, S.K.; Lo, A.C.Y.; Fung, M.L.; Chan, Y.S.; et al. Antidepressant-like effects of transcorneal electrical stimulation in rat models. Brain Stimul. 2022, 15, 843–856. [Google Scholar] [CrossRef]
- Venturella, G.; Ferraro, V.; Cirlincione, F.; Gargano, M.L. Medicinal Mushrooms: Bioactive Compounds, Use, and Clinical Trials. Int. J. Mol. Sci. 2021, 22, 634. [Google Scholar] [CrossRef]

| Authors | Disease, Clinical Phase, and Duration | Research Design | Administration Method | Dosage | Outcome Measures | Clinical Evaluation | Adverse Effects |
|---|---|---|---|---|---|---|---|
| Li et al., 2020 [60] | Mild Alzheimer’s disease Completed 52 weeks | Double-blind, two parallel groups, randomized, placebo-controlled 49 participants, 50 to 90 years old | Oral route | 350 mg mycelia-based capsule containing 5 mg/g of erinacine A per day or identically appearing placebo capsules | Significant improvement in MMSE, IADL, CASI scores, and better contrast sensitivity than placebo HE-A was well-tolerated, safe, and improved cognitive function | Adverse events evaluation NPI MMSE CASI IADL Ophthalmic examination Biomarker collection Neuroimaging | 1 subject lost to follow-up 3 subjects lost to unsatisfactory efficacy 4 subjects lost to side effects: nausea, abdominal discomfort, nausea, and skin rash |
| Mori et al., 2009 [61] | Mild cognitive impairment Completed 22 weeks | Double-blind, parallel group, placebo-controlled trial, randomized 30 participants, 50 to 80 years old | Oral route | Four 250 mg tablets of dry powder of HE (96% of HE) or three placebo tablets per day for 16 weeks | Improved cognitive function scale scores | HDS-R Adverse effect evaluation Blood chemistry | N.A. |
| Saitsu et al., 2019 [62] | Normal cognitive functions Completed 12 weeks | Double-blind, placebo-controlled trial, parallel group, randomized 34 participants, 50 years old and above | Oral route | Four HE supplements containing 0.8 g of powdered fruiting body or four placebo supplements per day for 12 weeks | Significantly improved cognitive functions in MMSE | MMSE Benton visual retention test S-PA | N.A. |
Publisher’s Note: MDPI stays neutral with regard to jurisdictional claims in published maps and institutional affiliations. |
© 2022 by the authors. Licensee MDPI, Basel, Switzerland. This article is an open access article distributed under the terms and conditions of the Creative Commons Attribution (CC BY) license (https://creativecommons.org/licenses/by/4.0/).
Share and Cite
Yanshree; Yu, W.S.; Fung, M.L.; Lee, C.W.; Lim, L.W.; Wong, K.H. The Monkey Head Mushroom and Memory Enhancement in Alzheimer’s Disease. Cells 2022, 11, 2284. https://doi.org/10.3390/cells11152284
Yanshree, Yu WS, Fung ML, Lee CW, Lim LW, Wong KH. The Monkey Head Mushroom and Memory Enhancement in Alzheimer’s Disease. Cells. 2022; 11(15):2284. https://doi.org/10.3390/cells11152284
Chicago/Turabian StyleYanshree, Wing Shan Yu, Man Lung Fung, Chi Wai Lee, Lee Wei Lim, and Kah Hui Wong. 2022. "The Monkey Head Mushroom and Memory Enhancement in Alzheimer’s Disease" Cells 11, no. 15: 2284. https://doi.org/10.3390/cells11152284
APA StyleYanshree, Yu, W. S., Fung, M. L., Lee, C. W., Lim, L. W., & Wong, K. H. (2022). The Monkey Head Mushroom and Memory Enhancement in Alzheimer’s Disease. Cells, 11(15), 2284. https://doi.org/10.3390/cells11152284

